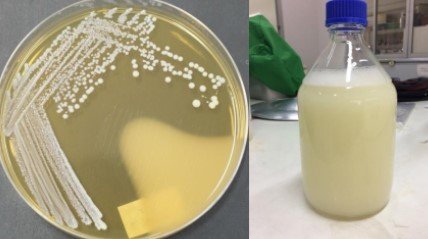

รายละเอียดนวัตกรรม
ความรู้ / เทคโนโลยี
-
จุดเด่น
1.ระบบบริหารจัดการงานวิจัยแบบครบวงจรและเป็นระบบ
2.กลไกสนับสนุนงานวิจัยอย่างรอบด้าน
3.การติดตามและประเมินผลเชิงพัฒนา (Developmental Evaluation)
4.การยกระดับคุณภาพและศักยภาพนักวิจัย
5.ส่งเสริมการพัฒนาศักยภาพคณาจารย์และบุคลากรด้านการวิจัย
6.การบริหารจัดการเชิงยุทธศาสตร์และการใช้ประโยชน์จากงานวิจัย
2.กลไกสนับสนุนงานวิจัยอย่างรอบด้าน
3.การติดตามและประเมินผลเชิงพัฒนา (Developmental Evaluation)
4.การยกระดับคุณภาพและศักยภาพนักวิจัย
5.ส่งเสริมการพัฒนาศักยภาพคณาจารย์และบุคลากรด้านการวิจัย
6.การบริหารจัดการเชิงยุทธศาสตร์และการใช้ประโยชน์จากงานวิจัย
รายละเอียดเพิ่มเติม
โพรไบโอติก (Probiotics) คือ จุลินทรีย์ที่ได้รับการยอมรับว่าปลอดภัย และก่อประโยชน์ให้กับสุขภาพของผู้บริโภค เมื่อได้รับเข้าไปในร่างกายในปริมาณที่เหมาะสม หรือช่วยปรับสภาพความสมดุลของจุลินทรีย์ในระบบทางเดินอาหารและลำไส้ผลการศึกษาสามารถคักแยกเชื้อ
ปัญหาและประโยชน์ (Pain & Gain)
ปัญหา (Pain Points)
-
--
ประโยชน์ (Gain Points)
-
--
กลุ่มเป้าหมาย
รายละเอียดกลุ่มเป้าหมาย
ภาคประชาชน/สังคม
ประวัติการได้รับทุนสนับสนุน
| ปีงบฯ | ชื่อแหล่งทุน | ประเภท |
|---|---|---|
| วิจัย |
พิกัดแผนที่
กำลังโหลดแผนที่...
ผลลัพธ์และผลกระทบเชิงประจักษ์
ROI (Economic)
ตัวชี้วัด:
ปริมาณ: 0
SROI (Social)
ตัวชี้วัด:
ปริมาณ:

